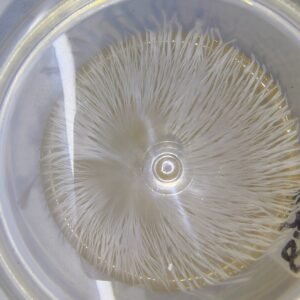
VARIEDADES EXOTICAS O ALBINAS DESDE

VARIEDADES EXOTICAS O ALBINAS DESDE
$120.000Las petris de hongos son esenciales para quienes buscan cultivar y estudiar hongos de forma precisa y efectiva. Perfectas para proyectos científicos o para la producción de hongos comestibles y medicinales, estas placas de laboratorio ofrecen un entorno controlado donde tus hongos pueden crecer y desarrollarse al máximo. ¡Lleva tu cultivo al siguiente nivel con…